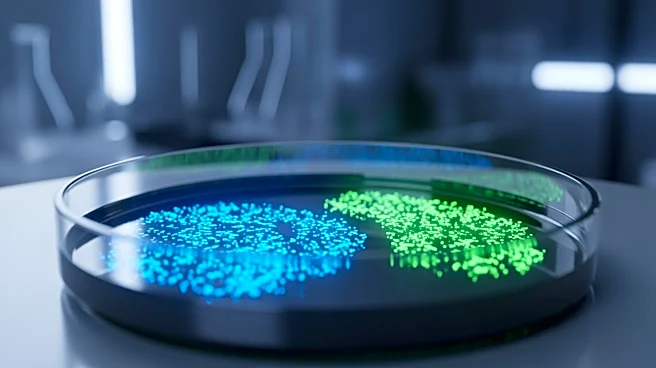

What's Happening?
Intellia Therapeutics has announced that its Crispr-based treatment for hereditary angioedema has met its goals in a late-stage trial. The treatment, which edits DNA in vivo to turn off a gene causing overproduction of a peptide, reduced swelling attacks
by 87% compared to a placebo. This marks a significant milestone in gene editing, as it is the first Phase 3 data for in vivo Crispr treatment. The company plans to seek FDA approval and aims to launch the treatment in the U.S. next year.
Why It's Important?
This development represents a major advancement in the field of gene editing, demonstrating the potential of in vivo Crispr treatments to address genetic disorders. If approved, Intellia's treatment could offer a one-time solution for hereditary angioedema, providing an alternative to existing chronic therapies. The success of this trial could pave the way for further applications of Crispr technology in treating other genetic conditions, potentially revolutionizing personalized medicine and offering new hope to patients with rare diseases.
What's Next?
Intellia is in the process of completing its FDA application and anticipates launching the treatment in the first half of next year, pending approval. The company will likely continue to monitor the long-term effects of the treatment and explore its application to other genetic disorders. The outcome of this approval process could influence the future of gene editing therapies and their integration into mainstream medical practice.